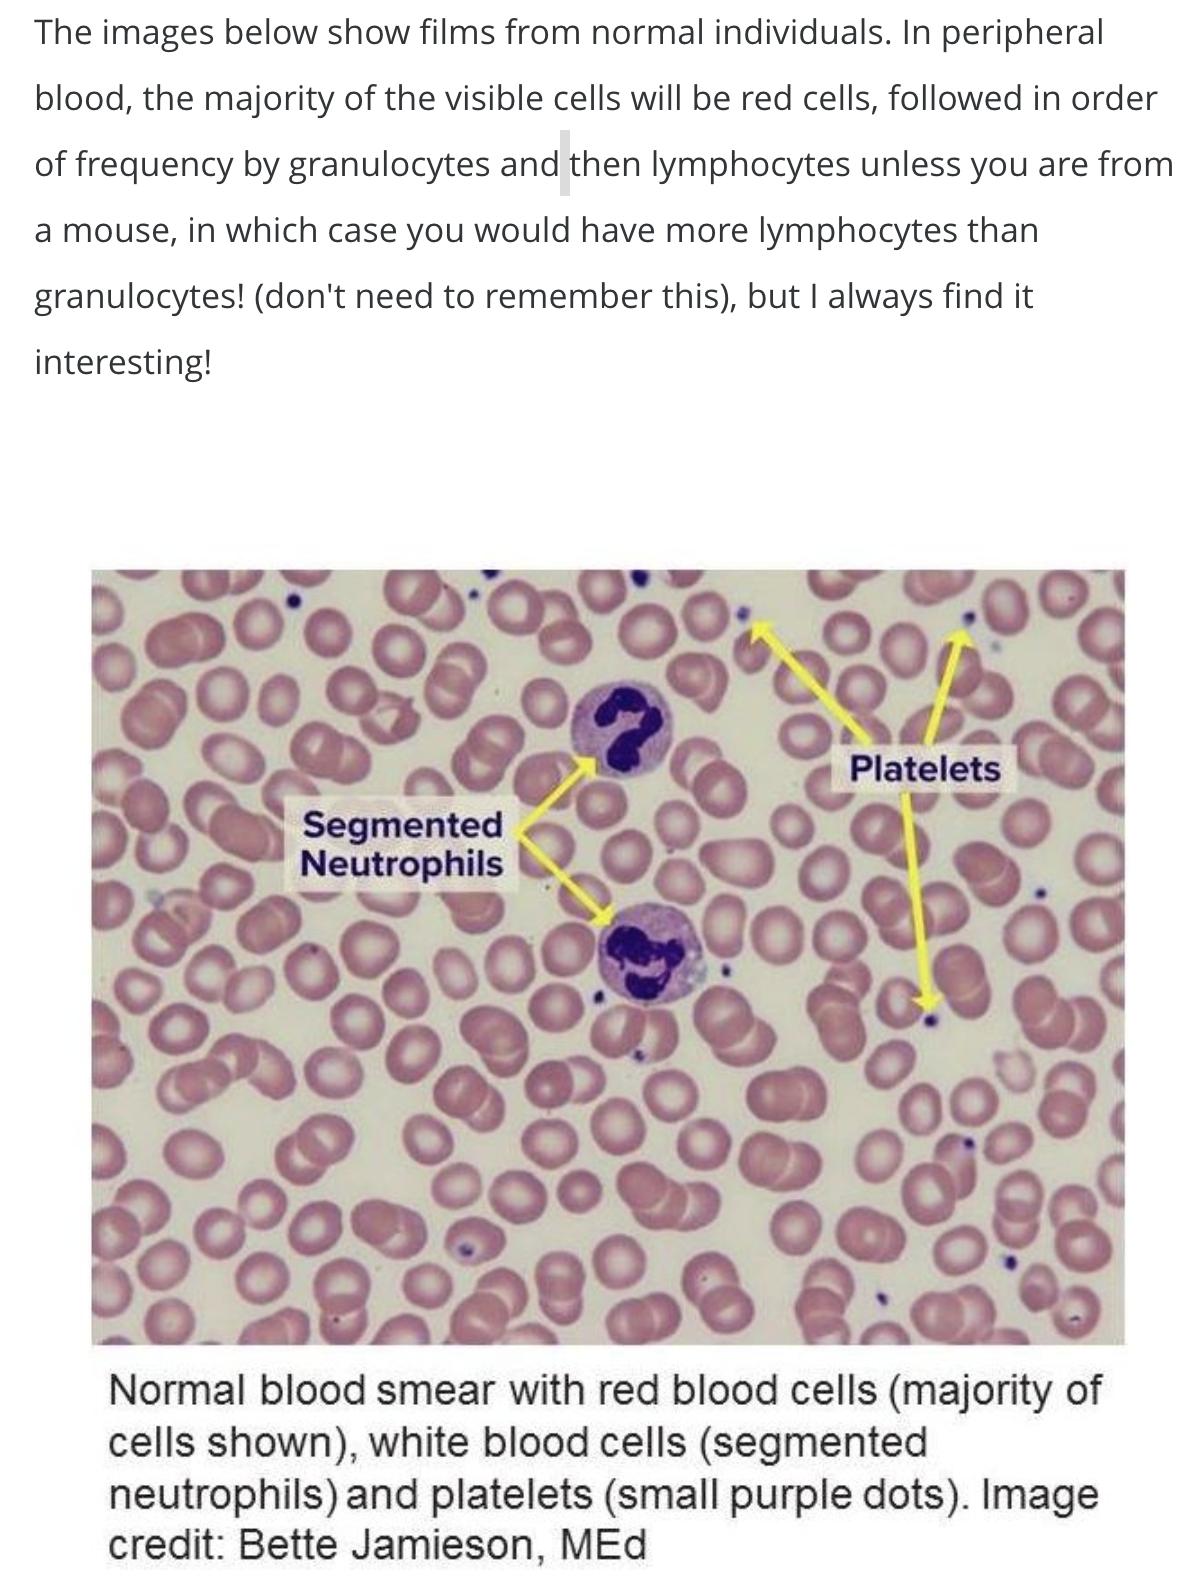

Define morphology
What is flow cytometry?
What is cytogenetics?
What is PCR?
What is next generation sequencing?
Observe what a blood smear looks like

Familarise yourself with the blood smears from normal individuals (1)

Familarise yourself with the blood smears from normal individuals (2)

Observe this megakaryocyte in the BM

Observe the different stages of maturation in the BM

What is flow cytometry?
What are the steps?

Explain how foward scatter works (in relation to flow cytometry)
Explain how side scatter works (in relation to flow cytometry)
Describe the main steps of flow-cytometry:

How does the computer analyse flow cytometry data?

Describe how flow cytometry works?

Observe this flow cytometry image

What is immunophenotyping?


What are the preparation steps in cytogenetics?

What is successful cytogenetics dependent on?
What is the solution of this
What is Giemsa banding (G-banding) in cytogenetics?

When is cytogenetics not able to diagnose a genetic abnormality?
What is Florescence in situ hybridisation (FISH)?
